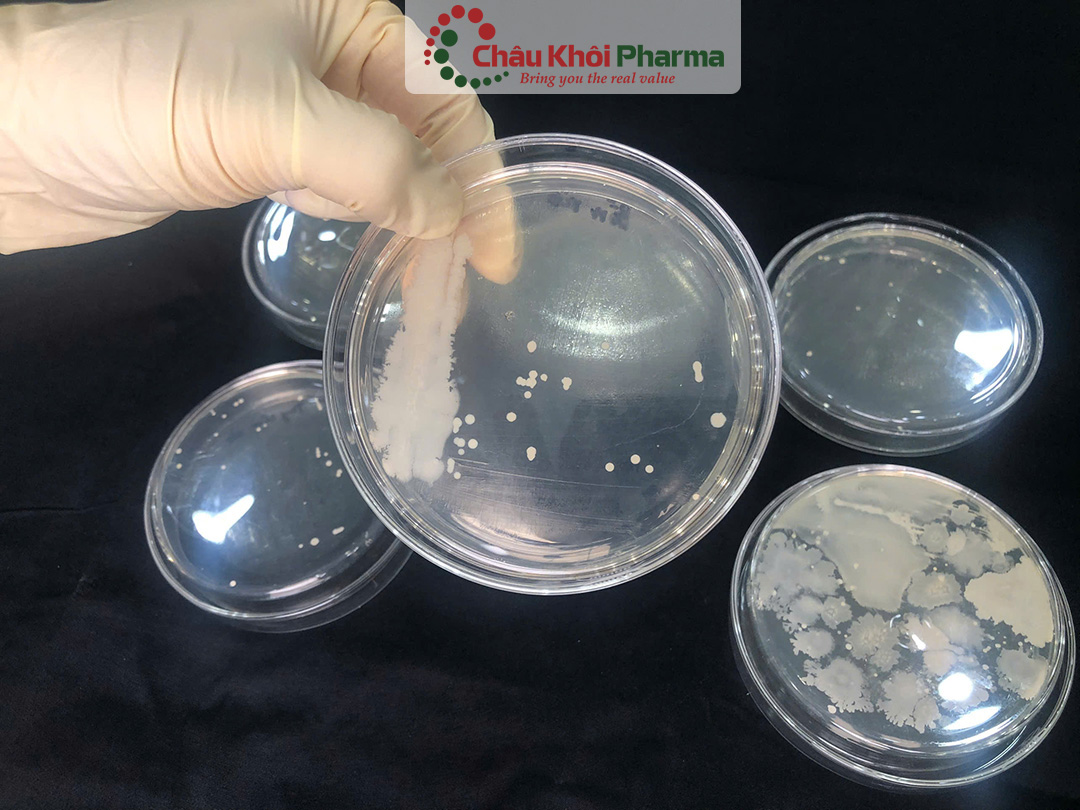
tư vấn kiểm soát chất lượng sản phẩm tại Hà Nội

I. Kiểm soát chất lượng sản phẩm là gì?

Kiểm soát chất lượng sản phẩm (Quality Control - QC) là một quy trình quan trọng giúp doanh nghiệp đảm bảo sản phẩm đáp ứng các tiêu chuẩn chất lượng đề ra. Mục tiêu chính của kiểm soát chất lượng là phát hiện và ngăn chặn các lỗi trong quá trình sản xuất, từ đó nâng cao độ bền, tính an toàn và hiệu suất sử dụng của sản phẩm.
Tại Hà Nội, nhu cầu tư vấn kiểm soát chất lượng sản phẩm ngày càng tăng cao, đặc biệt trong các ngành sản xuất và kinh doanh. Việc áp dụng các phương pháp kiểm soát chất lượng hiệu quả không chỉ giúp doanh nghiệp tuân thủ các quy định pháp lý mà còn nâng cao uy tín thương hiệu, tối ưu hóa chi phí sản xuất và gia tăng sự hài lòng của khách hàng.
Các quy trình kiểm soát chất lượng thường bao gồm:
-
Kiểm tra nguyên liệu đầu vào
-
Giám sát quy trình sản xuất
-
Tư vấn đơn vị kiểm định sản phẩm trước khi đưa ra thị trường
-
Đánh giá và cải tiến liên tục hệ thống quản lý chất lượng
Doanh nghiệp có thể tìm đến các đơn vị tư vấn kiểm soát chất lượng sản phẩm tại Hà Nội uy tín, chuyên nghiệp để được hỗ trợ xây dựng hệ thống kiểm soát phù hợp với tiêu chuẩn ISO, GMP, HACCP và các quy định khác. Điều này giúp đảm bảo chất lượng sản phẩm, tăng cường năng lực cạnh tranh và phát triển bền vững.
Xem thêm: Đơn vị tư vấn chất lượng sản xuất sản phẩm tại Hà Nội
II. Các phương pháp tư vấn kiểm soát chất lượng sản phẩm tại Hà Nội

Để đảm bảo sản phẩm đạt tiêu chuẩn chất lượng cao, các doanh nghiệp cần áp dụng những phương pháp kiểm soát chất lượng hiệu quả. Dưới đây là các phương pháp phổ biến giúp tối ưu hóa quy trình sản xuất và nâng cao chất lượng sản phẩm:
-
Kiểm soát quy trình bằng thống kê (SPC): Phương pháp này dựa trên việc thu thập và phân tích dữ liệu sản xuất nhằm phát hiện và khắc phục lỗi ngay từ giai đoạn đầu, giúp giảm thiểu rủi ro trong sản xuất.
-
Phương pháp Six Sigma: Đây là chiến lược quản lý chất lượng nhằm giảm thiểu sai sót xuống mức thấp nhất bằng cách sử dụng các công cụ phân tích dữ liệu để cải tiến quy trình sản xuất.
-
Phương pháp 5S: Hệ thống 5S gồm: Sàng lọc (Seiri), Sắp xếp (Seiton), Sạch sẽ (Seiso), Săn sóc (Seiketsu) và Sẵn sàng (Shitsuke), giúp tạo môi trường làm việc khoa học, giảm thiểu lãng phí và nâng cao năng suất.
-
Phương pháp Kaizen: Đây là chiến lược cải tiến liên tục, khuyến khích tất cả nhân viên trong doanh nghiệp đóng góp ý tưởng nhằm tối ưu hóa quy trình sản xuất và kiểm soát chất lượng sản phẩm.
-
Đảm bảo chất lượng (QA - Quality Assurance): QA tập trung vào việc xây dựng tiêu chuẩn và quy trình kiểm soát chất lượng ngay từ đầu, đảm bảo sản phẩm đạt yêu cầu trước khi đến tay khách hàng.
-
Mô hình quản lý chất lượng sản phẩm (MQA - Manufacturing Quality Assurance): Phương pháp này giúp doanh nghiệp giám sát toàn bộ quá trình sản xuất, từ kiểm tra nguyên liệu đầu vào đến kiểm định sản phẩm cuối cùng, đảm bảo sản phẩm đạt chuẩn trước khi phân phối ra thị trường.
-
Kiểm soát chất lượng toàn diện (TQC - Total Quality Control): Đây là mô hình quản lý chất lượng tổng thể, bao gồm tất cả các khâu từ nghiên cứu, phát triển sản phẩm, sản xuất, phân phối đến chăm sóc khách hàng, giúp tối ưu hóa chất lượng và nâng cao sự hài lòng của khách hàng.
Với sự hỗ trợ từ các chuyên gia tư vấn kiểm soát chất lượng sản phẩm tại Hà Nội, doanh nghiệp có thể lựa chọn phương pháp phù hợp, xây dựng quy trình kiểm soát chất lượng chặt chẽ và nâng cao năng lực cạnh tranh trên thị trường.
Xem thêm: Tư vấn kiểm soát thành phần sinh học chất lượng hàng đầu tại Thanh Xuân Hà Nội
III. Lợi ích khi áp dụng tư vấn kiểm soát chất lượng sản phẩm tại Hà Nội

Kiểm soát chất lượng sản phẩm đóng vai trò quan trọng trong sự phát triển bền vững của doanh nghiệp. Dưới đây là những lợi ích nổi bật khi áp dụng các giải pháp tư vấn kiểm soát chất lượng sản phẩm tại Hà Nội:
Nâng cao lòng trung thành của khách hàng
Sản phẩm chất lượng cao giúp doanh nghiệp xây dựng uy tín và gia tăng sự tin tưởng của khách hàng. Khi khách hàng hài lòng, họ không chỉ tiếp tục mua hàng mà còn giới thiệu sản phẩm đến nhiều người khác, giúp doanh nghiệp mở rộng thị phần.
Giảm chi phí sửa chữa và đổi trả sản phẩm
Kiểm soát chất lượng hiệu quả giúp phát hiện lỗi ngay từ đầu, giảm thiểu rủi ro hàng hóa bị lỗi sau khi sản xuất. Điều này giúp doanh nghiệp tiết kiệm chi phí sửa chữa, hoàn trả sản phẩm và tránh các khiếu nại từ khách hàng.
Tối ưu hóa quy trình sản xuất
Kiểm soát chất lượng giúp loại bỏ những lãng phí không cần thiết, tối ưu hóa hiệu suất làm việc và đảm bảo sản phẩm được sản xuất theo quy trình đạt chuẩn. Nhờ đó, doanh nghiệp có thể cải thiện năng suất và giảm thiểu thất thoát nguyên vật liệu.
Cải thiện độ an toàn của sản phẩm
Đối với các ngành thực phẩm, dược phẩm, điện tử hay sản xuất công nghiệp, kiểm soát chất lượng giúp đảm bảo sản phẩm không gây nguy hại cho người tiêu dùng. Điều này góp phần bảo vệ sức khỏe khách hàng và nâng cao hình ảnh thương hiệu.
Gia tăng uy tín thương hiệu
Một doanh nghiệp có sản phẩm đạt tiêu chuẩn chất lượng sẽ dễ dàng xây dựng danh tiếng trên thị trường. Uy tín này không chỉ thu hút khách hàng mà còn tạo dựng niềm tin với đối tác, nhà đầu tư, giúp doanh nghiệp phát triển bền vững.
Tuân thủ các quy định pháp lý
Áp dụng kiểm soát chất lượng giúp doanh nghiệp đáp ứng các tiêu chuẩn an toàn, môi trường và các quy định pháp luật. Điều này giúp tránh các rủi ro pháp lý, đồng thời tạo lợi thế cạnh tranh khi mở rộng thị trường.
Xem thêm: Tư vấn kiểm soát chất lượng hoa quả tại Thanh Xuân Hà Nội
IV. Quy trình tư vấn kiểm soát chất lượng sản phẩm tại Hà Nội

Để đảm bảo sản phẩm đạt tiêu chuẩn cao nhất, doanh nghiệp cần áp dụng một quy trình kiểm soát chất lượng nghiêm ngặt. Dưới đây là các bước quan trọng trong quy trình tư vấn kiểm soát chất lượng sản phẩm tại Hà Nội giúp doanh nghiệp nâng cao chất lượng sản phẩm và đáp ứng yêu cầu thị trường.
Xác định tiêu chuẩn chất lượng sản phẩm
Mỗi loại sản phẩm đều có những tiêu chuẩn chất lượng riêng biệt. Doanh nghiệp cần xác định rõ các yếu tố cần kiểm tra như:
Độ bền và tính năng sản phẩm
Độ an toàn khi sử dụng
Thiết kế, mẫu mã, kích thước
Tiêu chuẩn kỹ thuật theo quy định của ngành
Việc thiết lập các tiêu chuẩn này giúp đảm bảo mọi sản phẩm trước khi sản xuất hoặc phân phối đều đạt chất lượng tối ưu.
Lựa chọn phương pháp kiểm soát chất lượng phù hợp
Mỗi ngành hàng sẽ có phương pháp kiểm tra chất lượng khác nhau. Doanh nghiệp cần áp dụng phương pháp kiểm tra phù hợp, bao gồm:
-
Kiểm tra trực quan: Đánh giá hình thức, mẫu mã, màu sắc sản phẩm
-
Kiểm tra vật lý: Đo lường độ bền, chịu lực, chống thấm, chịu nhiệt…
-
Kiểm tra hóa học: Phân tích thành phần nguyên liệu, mức độ an toàn
Việc cập nhật và cải tiến phương pháp kiểm tra theo sự phát triển của công nghệ giúp tối ưu hiệu quả kiểm soát chất lượng.
Tiến hành kiểm tra chất lượng trong từng công đoạn sản xuất
Sản phẩm cần được kiểm tra xuyên suốt quá trình sản xuất để phát hiện sớm các lỗi sai. Các doanh nghiệp thường áp dụng:
-
Kiểm tra nguyên liệu đầu vào
-
Kiểm soát chất lượng trong quá trình sản xuất
-
Kiểm tra sản phẩm hoàn thiện trước khi xuất xưởng
Những sản phẩm không đạt tiêu chuẩn sẽ bị loại bỏ hoặc điều chỉnh ngay, ngăn chặn sản phẩm kém chất lượng ra thị trường.
Đào tạo và nâng cao kỹ năng đội ngũ kiểm tra chất lượng
Nhân viên kiểm soát chất lượng cần được đào tạo bài bản về các tiêu chuẩn, phương pháp và công cụ kiểm tra hiện đại. Việc nâng cao trình độ chuyên môn giúp đảm bảo quy trình kiểm soát chất lượng diễn ra hiệu quả và chính xác.
Xây dựng hệ thống báo cáo và xử lý lỗi kịp thời
Hệ thống báo cáo chất lượng giúp doanh nghiệp theo dõi và phân tích các lỗi sản phẩm, từ đó tìm ra nguyên nhân và đưa ra phương án khắc phục nhanh chóng. Những lỗi nhỏ có thể được sửa chữa ngay trong dây chuyền sản xuất, trong khi các lỗi nghiêm trọng có thể yêu cầu điều chỉnh toàn bộ quy trình để đảm bảo chất lượng đầu ra.
V. Châu Khôi Pharma – Đơn vị tư vấn kiểm soát chất lượng sản phẩm tại Hà Nội chuyên nghiệp, uy tín
Trong bối cảnh thị trường ngày càng cạnh tranh, việc đảm bảo chất lượng sản phẩm là yếu tố quyết định giúp doanh nghiệp xây dựng uy tín thương hiệu và thu hút khách hàng. Nếu bạn đang tìm kiếm dịch vụ tư vấn kiểm soát chất lượng sản phẩm tại Hà Nội, Châu Khôi Pharma là một trong những đơn vị hàng đầu với kinh nghiệm chuyên sâu trong lĩnh vực này.
Châu Khôi Pharma – Chuyên gia kiểm soát chất lượng sản phẩm
Với đội ngũ chuyên gia gồm dược sĩ, tiến sĩ có nhiều năm kinh nghiệm, Châu Khôi Pharma cam kết mang đến giải pháp tư vấn tối ưu cho các doanh nghiệp trong các ngành:
-
Mỹ phẩm: Đảm bảo thành phần an toàn, tuân thủ tiêu chuẩn GMP và các quy định hiện hành.
-
Thực phẩm chức năng: Kiểm tra chất lượng nguyên liệu, quy trình sản xuất và hiệu quả sản phẩm.
-
Thực phẩm bổ sung: Đánh giá thành phần dinh dưỡng, an toàn vệ sinh thực phẩm và khả năng hấp thụ.
Các chuyên gia tại Châu Khôi Pharma không chỉ nắm vững về công thức sản phẩm mà còn cập nhật liên tục các tiêu chuẩn kiểm nghiệm và quy định pháp lý để giúp doanh nghiệp tuân thủ đúng quy định của Bộ Y tế.
Dịch vụ tư vấn kiểm soát chất lượng sản phẩm tại Hà Nội của Châu Khôi Pharma
Kiểm tra thành phần và công thức sản phẩm
-
Đánh giá mức độ an toàn và hiệu quả của từng thành phần.
-
Đảm bảo sản phẩm đáp ứng các tiêu chuẩn chất lượng theo quy định pháp luật.
Tư vấn kiểm tra chất lượng
-
Đề xuất các phương pháp kiểm tra chất lượng ngay tại doanh nghiệp.
-
Giúp doanh nghiệp phát hiện sớm các lỗi sản phẩm trước khi đưa ra thị trường.
Giới thiệu đơn vị kiểm nghiệm đạt chuẩn
-
Hỗ trợ khách hàng lựa chọn phòng kiểm nghiệm đạt chuẩn ISO.
-
Kết nối với các đơn vị kiểm nghiệm uy tín được Bộ Y tế cấp phép.
Tối ưu chi phí sản xuất
-
Đánh giá giá thành sản phẩm.
-
Đề xuất phương án tối ưu chi phí nhưng vẫn đảm bảo chất lượng.
Hỗ trợ pháp lý và hồ sơ công bố sản phẩm
-
Cung cấp thông tin về hồ sơ công bố sản phẩm.
-
Hướng dẫn thủ tục pháp lý theo quy định hiện hành.
Kiểm soát chất lượng sản phẩm không chỉ giúp doanh nghiệp tuân thủ các quy định pháp lý mà còn góp phần nâng cao uy tín thương hiệu, gia tăng lòng tin của khách hàng và tối ưu hóa quy trình sản xuất. Nếu bạn đang tìm kiếm một đơn vị tư vấn kiểm soát chất lượng sản phẩm tại Hà Nội chuyên nghiệp, đáng tin cậy, hãy liên hệ ngay Châu Khôi Pharma để được các chuyên gia hàng đầu trong ngành hỗ trợ tư vấn toàn diện. Đầu tư vào chất lượng chính là đầu tư vào sự phát triển bền vững của doanh nghiệp!
CÔNG TY TNHH Y DƯỢC CHÂU KHÔI
-
Địa chỉ: Tầng 2 + Tầng 3, Số 85A Hạ Đình, Thanh Xuân Trung, Thanh Xuân, TP. Hà Nội
-
Hotline: 0904836693
-
Email: yduocchaukhoi@gmail.com
- Website: https://yduocchaukhoi.com/




